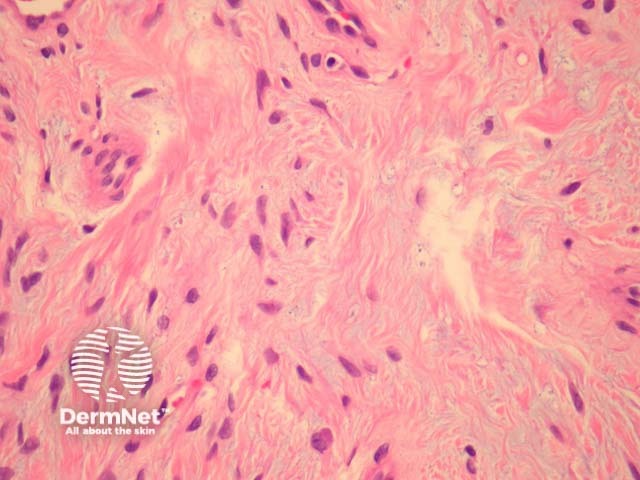
Figure 3

Main menu
Common skin conditions
NEWS
Join DermNet PRO
Read more
Quick links
Authors: Assoc Prof Patrick Emanuel, Dermatopathologist, Auckland, New Zealand, 2013.
Superficial acral fibromyxoma are benign fibromyxoid lesions. They are small isolated lesions with a predilection for the fingers, toes, and nails.
In superficial acral fibromyxoma, sections show a paucicellular fibromyxoid lesion arising in the dermis of acral skin (figure 1). Subcutaneous involvement is common. The cells are bland, spindled or stellate and set in a fibromyxoid stroma (figures 2 and 3).

Figure 1

Figure 2
Figure 3
Immunohistochemical studies of superficial acral fibromyxoma reveal positivity with CD34, EMA. S100, cytokeratins and smooth muscle markers are negative.
Neurofibroma – These also have a fibromyxoid stroma. S100 will be positive in neurofibroma.
Perineurioma – Sclerosing perineuroma often involves acral sites. Myxoid change is less common in these lesions. Both of these entities will be positive with EMA and negative with S100. Glut-1 positivity and CD34 negativity favours perineurioma.